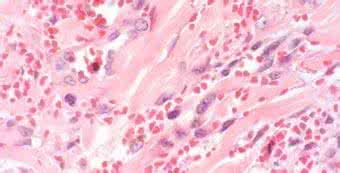
阴茎 珍珠状丘疹 阴茎珍珠状丘疹 它的危害大吗

阴茎珍珠状丘疹是一种发生在男性生殖器上的症状,很多男性同胞对此都很陌生,突然发现龟头起了一圈排列整齐的米粒大小的丘疹,也不知道是什么东西,但是却又不痛不痒,也无炎症反应,没有任何不适感。其实就像表面那样,对人体并没有什么危害,如果大家还是担心有什么问题,那我便仔细介绍一下阴茎珍珠状丘疹症状。
阴茎珍珠状丘疹是人体的一种生理性发育变异,对人体无碍,也不传染,可不必治疗。在成年男性中约24%有阴茎珍珠状丘疹,通常为一些珍珠状、红色、黄色或白色半透明丘疹,单个丘疹直径约1至3毫米,沿冠状沟排列成一行至数行,有时包绕整个冠状沟,丘疹排列常较整齐,不互相融合;而尖锐湿疣除常发于龟头和冠状沟外,也可发于包皮内侧、阴茎体皮肤和尿道口、肛门及肛周交界处,疣体数目少,多呈菜花状、乳头状或鸡冠状的疣状增生,这与只发于龟头冠状沟而排列整齐的珍珠状丘疹不同。
男性阴茎珍珠疹有什么危害?专家介绍说,阴茎珍珠状丘疹和假性湿疣与尖锐湿疣有些相似,但平时阴茎珍珠状丘疹或假性湿疣往往没有症状,因此常常不引起人们注意,而且这些丘疹在开始发育时便有了。
另外,人们对性病知识所知不多,不了解丘疹与尖锐湿疣的区别,后者是有潜伏期的,一般是在感染后(如与性病女性性交)3周至8个月,平均2至3个月才发病,不可能在性行为后马上发病。这样,一些人发现生殖器有异常就惊慌失措,又不去正规医院诊疗,结果往往上游医的当,本来不用治疗的,反而不但破财,而且无病治成有病。
由于珍珠疹没有炎性反应,没有瘙痒、没有溃破等表现,对男性的身体也不会有任何困扰,作为易患上该疾病的二十到三十岁的您,完全不用担心珍珠疹有什么危害。
如果真的要说珍珠疹的危害,可能就是会对患者的心理造成一定的伤害了。
看到这里,相信大家对于阴茎珍珠状丘疹已经有了足够的了解,它是一种良性疾病,有的人过段时间便会自己消除,而有的可能几年都没变化,但这种病症不妨碍健康,不处理也是没有问题的。但是患者要注意卫生,防止病症加重,是很重要的。
男人保养自己阴茎的16个小妙招
男性的生殖器常被称为命根子,因为它很重要且十分容易受伤,那么男人怎么保养自己的阴茎,才能让它保持健康呢?下面小编为您介绍男人怎么保养自己的阴茎,看看吧。
1、男性朋友要注意自己的日常睡姿,最好是仰卧比较好,因为男人侧睡会对睾丸处进行挤压,要相比站立时受到的挤压更明显,这样就会更容易发生睾丸扭转。睾丸上面有一根如同绳索一样的精索会扭转打结。由于给睾丸供应营养和运走代谢废物的血管从精索中通过,一旦精索打结后,睾丸就会挨饿,一般超过12个小时后会缺血坏死。
2、男性可在洗澡时或睡前双手按摩睾丸,拇指轻捏睾丸顺时、逆时各按摩十分钟,长期坚持必有益处。如在按摩时发现有异疼痛感,可能为睾丸炎或附睾炎,请及时到医院检查。
 爱华网
爱华网



